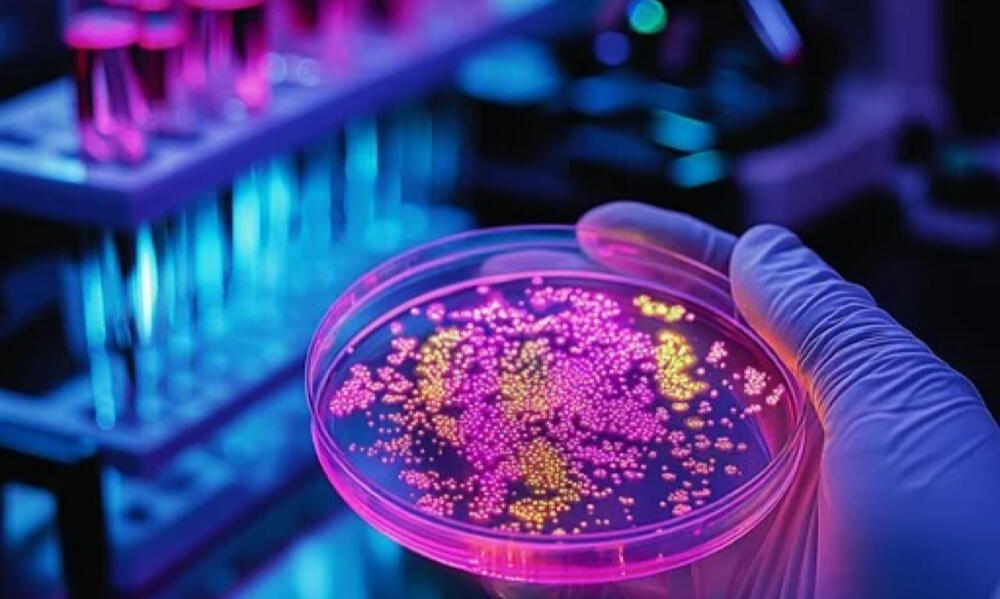

Quality • Integrity • Honesty
Welcome to CDO Enterprises, your dedicated consulting partner for comprehensive solutions.
Health
If you are looking to advance ideas in healthcare and innovation, we are here to help. Our team brings together a diverse range of expertise to support research, development, and the exploration of new possibilities in medicine and technology. Whether you are working on improving existing solutions or developing something entirely new, we can support you throughout the process. With a thoughtful and collaborative approach, we aim to simplify complex challenges and help turn ideas into meaningful outcomes. Let us be a reliable partner in your journey toward progress in medical innovation.
Investing
If you are in need of real estate consulting, look no further. Our team of experts can provide you with the guidance and advice you need to make informed decisions in the real estate market. Whether you are looking to buy, sell, or invest in property, we can assist you every step of the way. With our knowledge and expertise, we can help you navigate the complexities of the real estate industry and ensure that you make the best choices for your specific needs and goals. Let us be your trusted partner in real estate consulting.

Brand Awareness
Digital marketing consulting is essential for businesses looking to enhance their online presence and reach their target audience effectively. With our expertise in digital marketing strategies, we can provide valuable insights and guidance on how to optimize your online marketing efforts. Whether it's creating a social media strategy, improving SEO, or developing a content marketing plan, we can help you navigate the complex world of digital marketing to achieve your business goals. Contact us to learn how our digital marketing consulting services can benefit your business.

Get in Touch
If you are looking for expert consulting services, look no further than our team. Our experienced consultants are ready to help you with any challenges or questions you may have. Whether you need assistance with strategy development, problem-solving, or decision-making, we are here to provide you with the guidance and support you need. Contact us today to learn more about how our consulting services can benefit you and your business.
CDO Enterprises LLC
1021 E Lincolnway #570
Cheyenne, WY 82001
307-222-9611